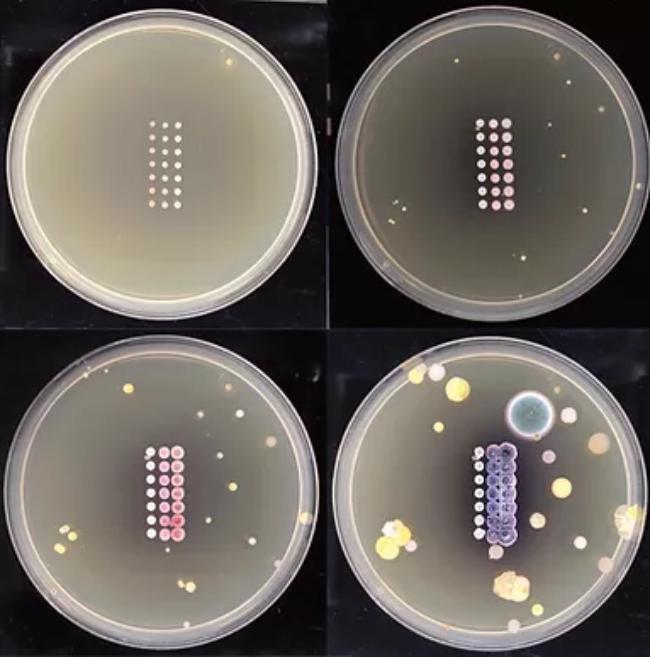
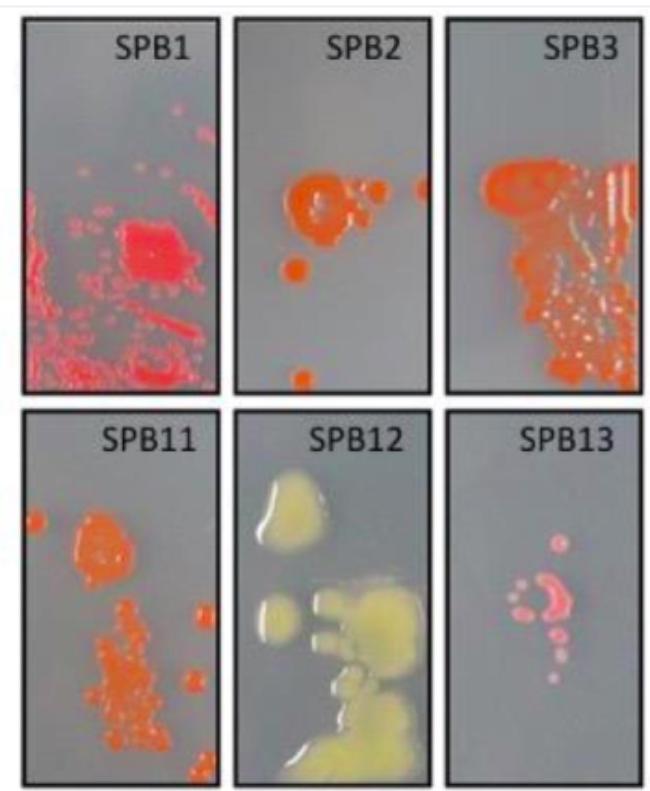

Dreaming About Art Strains in The San Francisco
I wanted to share some of the strains we've been researching. I live in the San Francisco Bay Area, and it's been a lot of fun looking into the interesting history of microbes in this area. Some of these might prove too difficult to find or impractical to isolate, but it's a good first pass and I'm excited to share what we've learned so far with you.
Nature
Fogedia krammeri is a species of diatom first described (Andrzej, et al. 2010) in the San Francisco Bay in 2002. Phytoplankton like this are a crucial part of the bay ecosystem - when they aren't doing well, the whole food chain suffers - fish, birds, and eventually humans. This is only one species out of many *many* species that fill The Bay. Their chlorophyll makes these diatoms a yellow-brown color, but other phytoplankton can be green or blue-green, which would look great in agar art.

Actinomycetes are a large group of filamentous bacteria, many of which live symbiotically (Willing, c., 2019) in the root structures of California Coast Redwoods. I love how these massive trees foster ecosystems of tiny, single-cell organisms. I've worked with a species in this group called S. coelicolor previously, and they do this really cool thing where they turn either a deep blue or red depending on the surrounding pH.
.png&width=650&height=)
Culture
Where would a discussion of San Francisco microbes be without sourdough yeast? Fructilactobacillus sanfranciscensis is one of the standout wild yeasts that give San Francisco sourdough its unique flavor. Studies have shown (Gobbetti and corsetti, 1997) it grows best at relatively cool temperatures, which might explain why they say it grows best in the San Francisco fog. It's brown, the usual color of yeast. But it's been shown to produce lactic acid, one of the molecules that give sourdough its sour-ness - I wonder if it would change the pH and color of S. coelicolor if it grew close by?
We sometimes think of human-made things as being separate from nature, but really everything interacts with everything else, including solar panels! A 2018 study (Porcar, et al., 2018) found a number of Hymenobacter species living on solar panels installed in Berkeley, CA. These species have to be hardy to withstand intense solar radiation, big temperature fluctuations, and dry conditions. Hymenobacter can be lovely shades of red, orange, and sometimes pink. These could be a striking addition to a microbial palette that represents the ways that humans and microbes affect each others' habitats.
Next steps for us are to reach out to experts in these species. As always, our first concern is biosafety. Once we feel we've identified safe strains for our labspaces, we'll look for protocols to isolate them effectively (What temperature do they grow at? What kind of nutrients do they need?). We'll also look for existing collections with interesting, artistic colors.
I hope these were interesting! What are your thoughts? What microbes are important where you live?
References
- Porcar, M. et al. Microbial Ecology on Solar Panels in Berkeley, CA, United States. Front. Microbiol. 9, 3043 (2018).
- M. Gobbetti, A. Corsetti, Lactobacillus sanfranciscoa key sourdough lactic acid bacterium:a review, Food Microbiology, Volume 14, Issue 2, 1997, Pages 175-187, ISSN 0740-0020, https://doi.org/10.1006/fmic.1996.0083.
- Willing, C. (2019). The Redwood Microbiome: Microbial community composition and functional consequences of plant-microbe interactions for the tallest species on Earth. UC Berkeley. ProQuest ID: Willing_berkeley_0028E_19064. Merritt ID: ark:/13030/m5353s4g. Retrieved from https://escholarship.org/uc/item/4jw1j1js
- Andrzej, Witkowski & Lange-Bertalot, Horst & Kociolek, Patrick & Kulikovskiy, Maxim & Bąk, Małgorzata & Ruppel, Manfred. (2010). Diatom flora of San Francisco bay and vicinity. II. Fogedia krammeri sp. nov. Polish Botanical Journal. 55. 49-53.